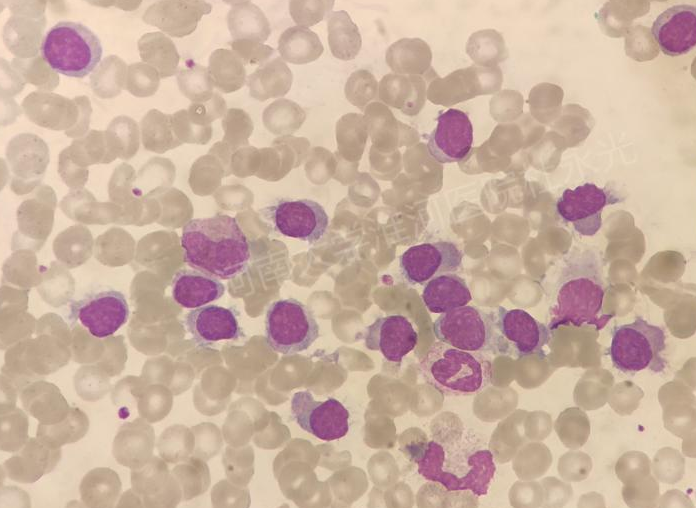
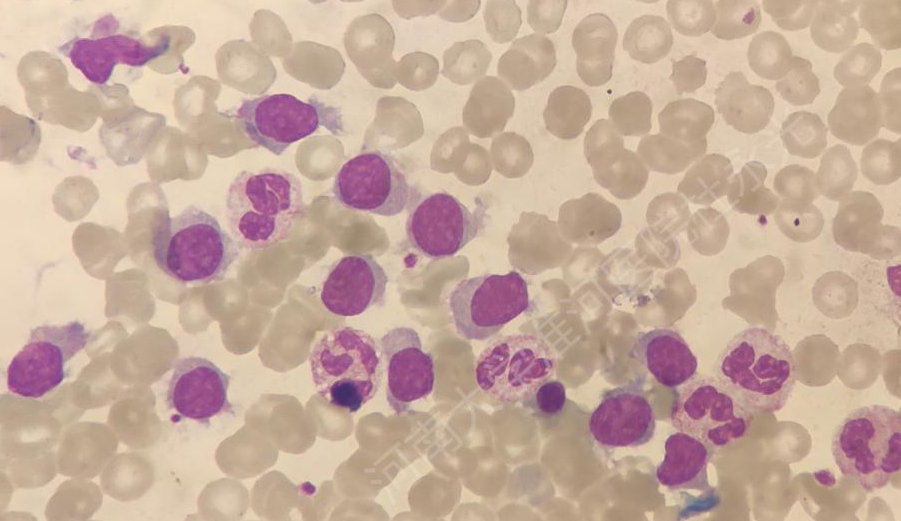

作者|杜永光
单位|河南大学淮河医院检验科
01
案例经过
一天上午我正在看骨髓涂片,临检的同事拿来了一张血涂片,说这个患者白细胞很高,并且散点图呈灰区,可能有异常细胞。我就先查看了该患者的血常规原始结果。

获取了敌方情报,开始分析:
1.高白细胞,单核细胞比例明显增高。
2.白细胞报警信息提示:白细胞散点图异常;中性粒、淋巴、单核、嗜碱、白细胞数均增多;幼稚粒;原始/异常淋巴细胞;不典型淋巴细胞。
3.WDF散点图提示淋、单区域融合且向原始细胞方向漂移;WNR散点图提示有少量有核红细胞。患者有可能是个白血病,需要涂片镜检。
MPO染色


我当时看到镜下这些细胞的时候,第一感觉像是原幼单核细胞,胞体大小较一致,胞浆丰富,淡蓝色,胞核圆形、椭圆形,稍显不规则。
但是这些细胞胞浆基本都没有颗粒,且多数细胞染色质有似淋系的那种涂抹感,并无原幼单核细胞的颗粒感,部分可见核仁。加做了过氧化物酶,这类细胞都是阴性的。
若是原幼淋的话胞浆一般不会那么多?原幼单?原幼淋?不好判断,那就先看下患者的病史以及其他检查,看能不能有提示。
患者男性,73岁。主诉:胸闷半月。
现病史:半月来患者无明显诱因出现胸闷不适,尤以夜间为主,伴心前区不适,端坐位好转。无发热、寒战、咳嗽、咳痰;无胸痛、心慌;无反酸、烧心、腹泻。就诊于当地县医院。
查血常规:WBC84×109/L;×1012/L;HB106g/L;PLT113×109/L,上腹部CT以及腹部彩超均提示脾脏明显增大并多发占位。急诊以“白细胞异常,脾大,脾占位”收入血液科。既往史、个人史等无异常。
查体:℃、P80次/分;R20次/分;Bp210/100mmHg.浅表淋巴结无肿大、肝肋下未触及、脾肋缘下4横指,其余无异常。
从患者当地的检查和入院的查体得到一个非常重要的信息:脾大,且基本达到巨脾的体征。
带着这个信息我又仔细的看了镜下细胞的特点,突然脑中闪过一道灵光,这些细胞像“煎鸡蛋”,且一开始我就怀疑染色质像淋系的,难道让我遇到了那种传说中的少见病——毛细胞白血病?
但毛白多数呈全血细胞减少的特点,这个患者却是个高白细胞,这点不太符合。不过变异型毛白往往是高白细胞、且患者的发病年龄也比较大,与该患者比较符合。
于是我就把自己的发现和思路与临床医生进行了沟通。但是医生说患者及家属并不打算在我院进行进一步的诊治,想回他老家治疗。哎!又是一例悬案。透心凉!患者出院后我也是耿耿于怀了好久。
“山穷水复疑无路,柳暗花明又一村”
此事过去将近一个月后的一天,早上刚到科室,夜班同事说夜里来个患者血常规异常,涂了片子让我看一下。我还是习惯性的先看了患者的血常规结果
诊断是脾占位性病变,白细胞很高,散点图灰区。那就镜检看看吧。

淋巴细胞,长毛的淋巴细胞。等等,患者名字好熟悉。是他,他又回来了……压抑住自己激动的心情,打开了患者的病历:这次患者是以“发现白细胞增高1月,左上腹疼痛8小时”为主诉入的院。
我赶快和临床医生联系,得知这次患者同意做血液病相关检查。一颗悬着的心终于落地了。虽然从两次入院血涂片的细胞形态观察,患者诊断变异型毛细胞白血病的可能性很大,但是确诊仍然需要综合诊断。几天后患者的相关检查结果陆续出来了:
胸部及上、下腹部CT:

骨穿结果:


流式结果:

染色体:

58种血液肿瘤突变基因:

由于患者个人原因,只做了以上血液相关检查,未做骨髓活检。不过结合患者的病史和各项检查综合诊断:变异型毛细胞白血病。
02
文献复习
毛细胞白血病(hairycellleukaemiaHCL)是一种少见的B淋巴细胞增殖性疾病,约占白血病的2%~3%,该病以毛细胞增殖、外周血循环淋巴细胞增加并浸润骨髓伴显著的脾肿大为特征[1]。在20世纪50年代首次作为一种独特的疾病被报道[2]。
HCL在欧美国家年发病率约为2.9/106,男性比较常见,男女比例为4:1,中位发病年龄为55岁(18~95岁)[3],亚洲人发病率明显低于欧美人。
HCL根据临床侵袭程度、细胞免疫表型及治疗反应等可分为两类,即经典型和变异型,国外报道变异型(hairycellvariantHCL-V)占全部HCL的10%左右,而国内王燕婴等[4]研究报道HCL-V则高达37.5%,这固然可能与诊断标准有关,但更可能是反映了国内外的差异。
临床表现和实验室特征:
2020年英国血液学学会(BSH)制订的HCL和HCL-V诊断和治疗指南[5]中总结了经典HCL诊断的临床和实验室特征。见表1(引自BSH制订的HCL和HCL-V诊断和治疗指南)

指南中还提到一些HCL患者常无症状,偶然发现全血细胞减少,其他表现为嗜睡或感染。大多数患者可伴有脾大,但症状性脾大不常见。
血常规常表现为两系细胞的减少,而白细胞减少是经典HCL的常见特征;单核细胞减少几乎总是存在的。相比之下,HCL-V常伴有白细胞增多,中性粒细胞、单核细胞也不减少。
经典型和变异型毛白外周血涂片均可见典型的毛细胞。有时也会呈现无毛的毛细胞,形态人把这种特点的毛细胞称为“煎蛋样”毛细胞。下图为BLOOD的一篇文章:“无毛”的毛细胞,外周血涂片毛细胞呈“煎蛋样”。

[6]说明:A外周血;B骨髓涂片;骨髓活检;D图为CD20染色)
免疫表型特点:
HCL的典型免疫表型CD5-、CD10-、CD20+、CD22+、CD11c+,CD103+、CD123+、CD25+、AnnexinA1+、CD200+,其中AnnexinA1表达最为特异;它不在任何其他B细胞淋巴瘤中表达,可用于区分经典HCL与HCL-V以及脾脏边缘区淋巴瘤。而HCL-V的CD25、CD123均不表达。
分子遗传学特点:
几乎所有的经典型HCL均有BRAFV600E突变,该突变于2011年通过全外显子组测序确定为HCL发病机制中的因果遗传事件[7],也被提议用来解释“毛状”形态。而HCL-V病例的BRAFV600E为阴性,MAP2K1是HCL-V最常突变的基因,并可能是未来一个潜在的治疗靶点[8]。
鉴别诊断方面:
除了HCL、HCL-V之间需要相互鉴别以外,还需要与脾边缘区淋巴瘤(SMZL)、脾弥漫性红髓小B细胞淋巴瘤(SDRPL)相鉴别,因为这几种淋巴瘤均为B细胞淋巴瘤,表达B系的免疫标记,常有脾大体征,外周血及骨髓也可见毛细胞。四种疾病的鉴别要点见下表(图表引自BSH制订的HCL和HCL-V诊断和治疗指南[5])
03
案例分析
学习了以上的文献:我们在来回顾分析一下该病例的诊断要点:患者为73岁老年男性,有脾大体征,从发病年龄上来看,依据表2中四种疾病的年龄特点,HCL-V和SMZL似乎更符合。HCL和SDRPL发病年龄相对年轻。
从白细胞数和细胞形态来看,该患者白细胞明显增高,且两次入院分别呈现了HCL两种不同的细胞形态学特点:无毛的“煎蛋样”毛细胞(SDRPL和SMZL的细胞并未有此形态特点)和有毛的典型毛细胞,(似HCL的周身有毛,并非SDRPL和SMZL的一端有毛),因此从白细胞数和形态特点来说,更倾向于HCL-V的诊断。
从免疫表型来看,该患者并未表达CD25、CD123.不是经典HCL的免疫表型,且流式也给出了HCL-V或SLVL的诊断。最后从分子遗传学结果看,58种基因检测并未有经典HCL常有的BRAFV600E突变,反而有HCL-V常见的MAP2K1突变。所以该患者结合病史、体征、血常规、细胞形态、流式免疫表型、分子遗传学综合诊断为HCL-V。
【参考文献】
[1]乔静巧,张姝婷,赵霄晨,白海.毛细胞白血病临床特征及相关实验室诊断分析(附13例)[J].现代肿瘤医学,2018,26(02):260-263.
[2]BouroncleBA,WisemanBK,[J].;13(7):609–30.
[3]QuestGR,JohnstonJB.Clinicalfeaturesanddiagnosisofhairycellleukemia[J].BestPractResClinHaematol,2015,28(4):180-192.
[4]王燕婴,李增军,易树华,等.40例毛细胞白血病临床特征分析[J].临床血液学杂志,2011,24(07):411-413.
[5](HCL)andhairycellvariant(HCL‐V)[J].BritishJournalofHaematology,2020,191(5):730-737.
[6]MoizB,QadirH."Hairless"hairycells[J].;123(26):4013
[7]TiacciE,TrifonovV,SchiavoniG,HolmesA,KernW,MartelliMP,[J].;364(24):2305–15.
[8]BoguszAM,:molecularpathology,clinicalrelevanceandtherapeutictargets[J].;57(9):1991–2013.